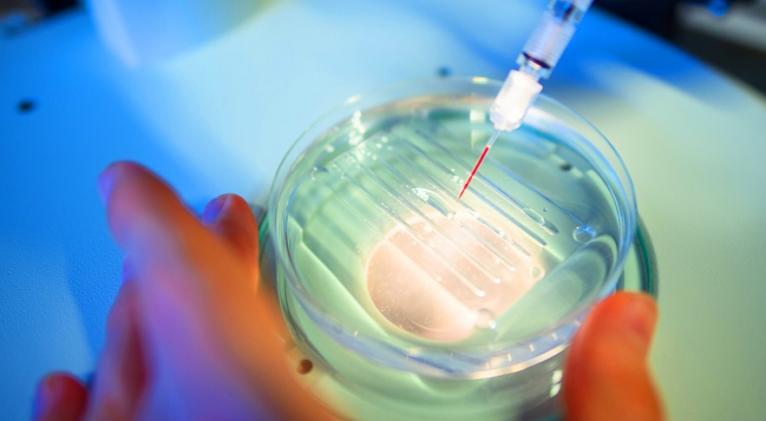

Descubren cómo eliminar el cromosoma que produce el síndrome de Down
especiales
Imagen tomada de https://actualidad-rt.com/
El síndrome de Down es un trastorno genético que se produce por la presencia de una copia extra del cromosoma 21, fenómeno conocido como trisomía 21, que genera alteraciones físicas y cognitivas en quien lo padece, como malformaciones cardíacas, pérdida auditiva y dificultades en el desarrollo del habla y del aprendizaje.
En este contexto, investigadores de la Universidad de Mie, en Japón, han realizado un avance significativo al aplicar una técnica de edición genética que podría eliminar por completo el cromosoma adicional.
El estudio, publicado en la revista PNAS Nexus, describe cómo se utilizó una herramienta llamada CRISPR-Cas9 para eliminar el exceso de cromosomas en las células afectadas y acercar el comportamiento celular a su función habitual.
Funcionamiento y perspectivas
CRISPR es un sistema de edición genética que utiliza una enzima para identificar secuencias específicas de ADN. Una vez que la enzima encuentra un sitio coincidente, elimina selectivamente la copia extra del cromosoma 21.
Este proceso, denominado edición específica de alelos, permite que la enzima de corte actúe solo sobre la trisomía sin afectar el resto del material genético.
Al hacerlo, los científicos observaron que la expresión génica se normalizaba y que las células corregidas mostraban un crecimiento más rápido y un tiempo de duplicación más corto en comparación con células no tratadas.
Además de trabajar con células en cultivo, el equipo aplicó su técnica a fibroblastos de la piel extraídos de personas con síndrome de Down, logrando nuevamente eliminar la trisomía en varios casos.
No obstante, dado que CRISPR aún puede afectar células sin anomalías, los investigadores continúan afinando su método para garantizar que la edición genética sea específica y segura.















Añadir nuevo comentario